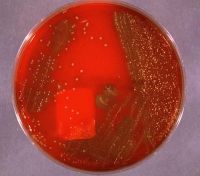

|
CDC Report Highlights "Superbugs"
Antibiotic-resistant pathogens use special
powers to fight crime
 |
|
Antibiotic-Resistant "Superbugs"
|
ATLANTA, GA--CDC Director Dr. Jeffrey Koplan stated
today that, despite the unfortunate recent increase in the incidence of
antibiotic-resistant "Superbugs," the combined efforts by these specially
empowered bacteria in fighting such evil fiends as Lex Luthor, Dr. Doom,
and the Joker, among others, "are substantial and worthy of praise."
 |
|
Evil Fiend
Lex Luthor
|
"Throughout the 1980s and 1990s, we have seen the
emergence of pathogens resistant to an increasing number of available
antibiotics. These 'Superbugs' threaten to erode the gains made against
communicable diseases in the 20th century." said Koplan in the 34-page
statement.
"However, it must be admitted that when Lex
Luthor was threatening to destroy Gotham City with his Megaton Death Ray,
it was the Superbugs who came to the rescue."
This was an apparent allusion to the February, 2000
incident during which the Superbugs, operating out of a diminutive "Hall
of Justice" located on a blood agar plate, attacked Luthor and gave him
a bad case of cellulitis just as he was about to pull the trigger. Luthor
had to be admitted to a local hospital, and the Death Ray was confiscated
by grateful authorities.
|
|
The Hall Of Justice
|
Similarly, a quinolone-resistant strain of Neiserria
gonorrhea was able to simultaneously disable both Catwoman and The
Penguin, who had been planning to rob gold bullion worth $100 million
from the First Gotham Bank.
Nonetheless, Koplan called on physicians to use greater
restraint in antibiotic prescribing, and asked the F.D.A. to look into
the burgeoning use of antimicrobials in agriculture.
Police Commisioner Gordon could not be reached for
comment.

|